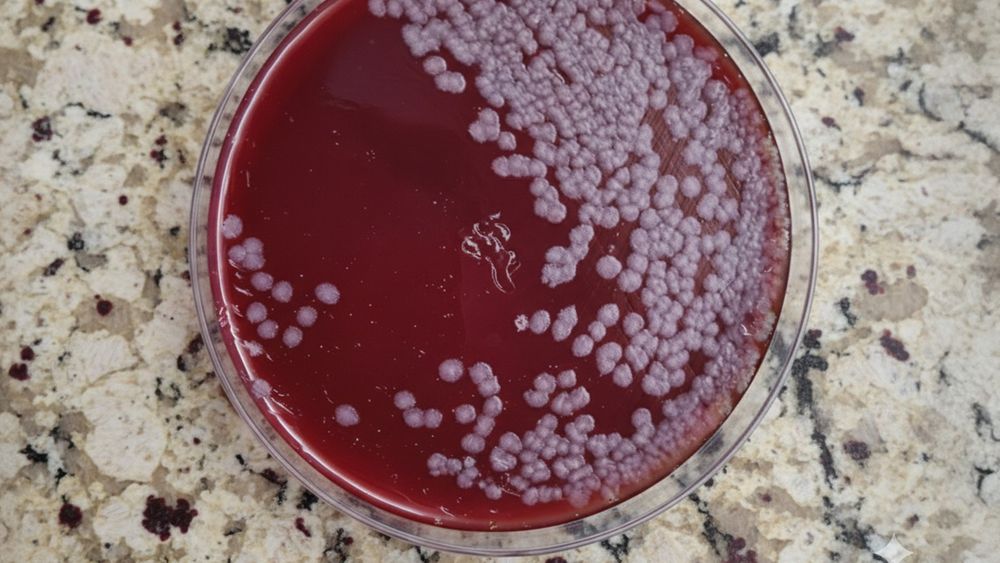
El Laboratorio Azul confirmó el diagnóstico de carbunclo en las muestras tomadas. El Laboratorio Azul confirmó el diagnóstico de carbunclo en las muestras tomadas.

Brote
Por Redacción de MOTIVAR¿Te interesa recibir Becas para jornadas y congresos técnicos?
Entre tensiones, cambios y decisiones, CIVA 2025 mostró el pulso real de la industria veterinaria y el nuevo modelo que se empieza a consolidar.
Con rotundo éxito, la Cumbre de la Industria Veterinaria reunió a más de 280 dueños, gerentes y referentes de laboratorios y distribuidoras veterinarias.
video




